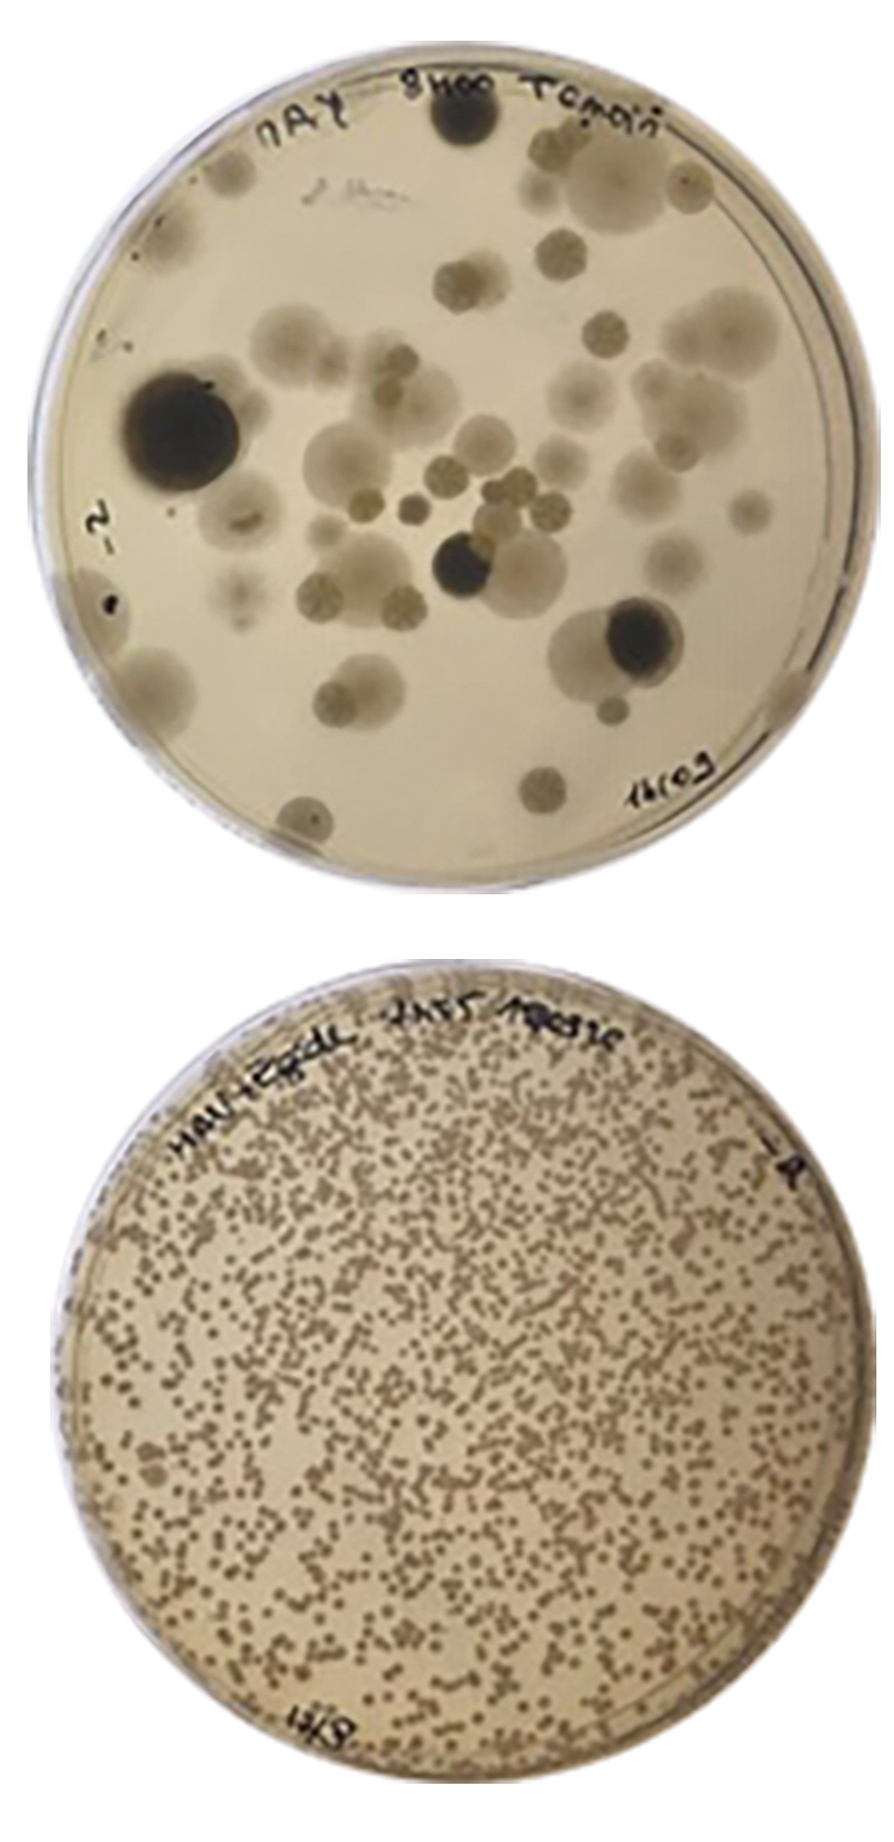

ZYMAFLORE® EGIDETDMP peut être
appliquée par pulvérisation sur matériel de récolte en contact avec le raisin (machine à vendanger, benne de vendange, réception vendange, citerne de transport des moûts, cagette de récolte etc.).

Cette pratique limite significativement la présence de micro-organismes potentiellement indésirables en colonisant la surface du matériel et les raisins tout au long de la journée de récolte.
DÉNOMBREMENT DE LA MICROFLORE DES RAISINS SUR MILIEU DE CULTURE « LEVURES TOTALES » :
(Pulvérisation préalable d’une solution de ZYMAFLORE® EGIDETDMP à 50 g/L sur machine à vendanger et benne de vendange).

Témoin sans BIOProtection : présence importante de moisissures et de micro-organismes potentiellement indésirables sur raisins en fin de journée de récolte.
BIOProtection avec ZYMAFLORE® ÉGIDETDMP : colonisation exclusive et progressive des raisins par ZYMAFLORE® ÉGIDETDMP durant la journée de récolte et absence de moisissures.
Sachet de 500g
Pour plus d’informations, Consultez notre focus sur notre site internet en cliquant ici !
LEVURE APPROUVÉE POUR L’INOCULATION DIRECTE